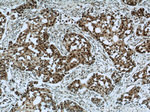
HDAC2 Antibody in Immunohistochemistry (Paraffin) (IHC (P))
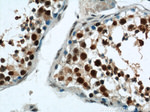
HDAC2 Antibody in Immunohistochemistry (Paraffin) (IHC (P))
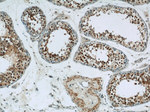
HDAC2 Antibody in Immunohistochemistry (Paraffin) (IHC (P))

Search
Proteintech
HDAC2 Polyclonal Antibody
{{$productOrderCtrl.translations['antibody.pdp.commerceCard.promotion.promotions']}}
{{$productOrderCtrl.translations['antibody.pdp.commerceCard.promotion.viewpromo']}}
{{$productOrderCtrl.translations['antibody.pdp.commerceCard.promotion.promocode']}}: {{promo.promoCode}} {{promo.promoTitle}} {{promo.promoDescription}}. {{$productOrderCtrl.translations['antibody.pdp.commerceCard.promotion.learnmore']}}
产品信息
12922-3-AP
种属反应
已发表种属
宿主/亚型
分类
类型
抗原
偶联物
形式
浓度
规格
纯化类型
保存液
内含物
保存条件
运输条件
产品详细信息
This antibody is a rabbit polyclonal antibody raised against residues near the C terminus of human HDAC2.
Immunogen sequence: TDRVMTVSF HKYGEYFPGT GDLRDIGAGK GKYYAVNFPM RDGIDDESYG QIFKPIISKV MEMYQPSAVV LQCGADSLSG DRLGCFNLTV KGHAKCVEVV KTFNLPLLML GGGGYTIRNV ARCWTHETAV ALDCEIPNEL PYNDYFEYFG PDFKLHISPS NMTNQNTPEY MEKIKQRLFE NLRMLPHAPG VQMQAIPEDA VHEDSGDEDG EDPDKRISIR ASDKRIACDE EFSDSEDEGE GGRRNVADHK KGAKKARIEE DKKETEDKKT DVKEEDKSKD NSGEKTDTKG TKSEQLSNP (274-571 aa encoded by BC031055)
靶标信息
HDAC2 belongs to the histone deacetylase family. Histone deacetylases act via the formation of large multiprotein complexes and are responsible for the deacetylation of lysine residues at the N-terminal regions of core histones (H2A, H2B, H3 and H4). This protein forms transcriptional repressor complexes by associating with many different proteins, including YY1, a mammalian zinc-finger transcription factor. Thus, it plays an important role in transcriptional regulation, cell cycle progression and developmental events. Alternative splicing results in multiple transcript variants.
仅用于科研。不用于诊断过程。未经明确授权不得转售。
生物信息学
蛋白别名: HD2; hdac 2; hdac-2; Histone deacetylase 2; Protein deacylase HDAC2; transcriptional regulator homolog RPD3; unnamed protein product; YY1 transcription factor-binding protein; YY1-associated factor 1
基因别名: D10Wsu179e; HD2; HDAC2; KDAC2; mRPD3; RPD3; YAF1; Yy1bp
UniProt ID: (Human) Q92769, (Mouse) P70288
Entrez Gene ID: (Human) 3066, (Mouse) 15182, (Rat) 84577